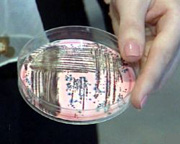

Британское правительство опубликовало досье, подтверждающее, что у Ирака есть планы по использованию химического и биологического оружия. Как отмечает AP, досье, основанное на данных британских спецслужб, было опубликовано за несколько часов до специального заседания парламента, посвященного возможным военным действиям против Ирака.
В досье говорится, что нет никаких сомнений в том, что Ирак продолжает разрабатывать химическое и биологическое оружие и пытается приобрести средства для производства ядерного оружия, а также увеличивает число баллистических ракет. Президент страны Саддам Хусейн напрямую контролирует разработку химического и биологического оружия, кроме того он пытался приобрести значительное количество урана в Африке.
Предыдущее пребывание в стране инспекторов ООН многому научило Ирак, и теперь страна готова предпринять необходимые меры, чтобы умело скрыть от международных инспекторов то, что в Ираке ведется разработка оружия массового уничтожения, говорится в досье. Досье также включает в себя карту, которая показывает, что оружие массового уничтожения может поразить Израиль, Ближний Восток, Грецию и Турцию. Если санкции ООН в отношении Ирака будут сняты, то Саддам Хусейн сможет разработать ядерное оружие за срок от 12 месяцев до двух лет, говорится в документах.
rbc